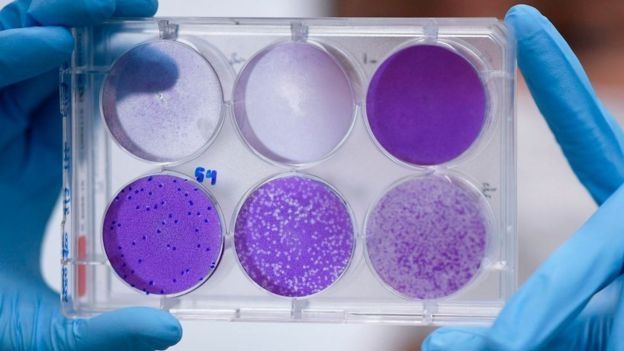

Covid-19: Hace 20 años, dejaron pasar la ocasión de obtener una vacuna

Posteriormente se descubrió que el patógeno que causaba la enfermedad era un coronavirus que se había originado en un animal y había pasado a los humanos.
En pocos meses, el coronavirus se propagó en 29 países, infectando a más de 8.000 personas y matando a unas 800.
Alrededor del mundo hubo un reclamo general para saber cuándo estaría lista una vacuna para acabar con el letal virus y decenas de científicos en Asia, Estados Unidos y Europa comenzaron a trabajar frenéticamente para crear la inoculación.
Surgieron varios candidatos, algunos de los cuales estaban listos para ser usados en ensayos clínicos.
Pero entonces se logró controlar la epidemia de SARS y el estudio de las vacunas contra el coronavirus fue abandonado.
Años después, en 2012, volvió a surgir otro letal coronavirus, el MERS-Cov, que causaba una grave enfermedad respiratoria, el MERS (síndrome respiratorio de Medio Oriente) que se originó en camellos y pasó a humanos.
Y muchos científicos volvieron a insistir en la necesidad de tener una vacuna contra estos patógenos.
Hoy casi 20 años después, cuando un nuevo coronavirus, el SARS-Cov-2, ya ha infectado a casi un millón y medio de personas, el mundo vuelve a preguntarse cuándo estará lista una vacuna.
¿Por qué no aprendimos de esos otros coronavirus si se sabe que pueden causar enfermedades tan letales en humanos como el Covid-19? Y ¿por qué no se siguieron estudiando las vacunas?
"No estamos interesados"
Un equipo de científicos en Houston, Texas, en Estados Unidos, sí siguió investigando, y en 2016 tenía una vacuna lista contra un coronavirus.
“Habíamos terminado los ensayos y habíamos pasado por el aspecto crítico de crear un proceso de producción de la vacuna a escala piloto”, le dice a BBC Mundo la doctora María Elena Bottazzi, codirectora de la Escuela Nacional de Medicina Tropical del Colegio Baylor de Medicina de Houston y codirectora del Centro para Desarrollo de Vacunas del Hospital Infantil de Texas, en Estados Unidos.
“Entonces fuimos a los NIH (Institutos Nacionales de Salud de EE.UU.) y les preguntamos: '¿Qué hacemos para mover rápido la vacuna a la clínica?' Y nos dijeron: 'Mira, ahorita no estamos ya interesados'”.
La vacuna era contra el coronavirus que provocó la epidemia de SARS de 2002, pero como aquella epidemia que surgió en China ya había sido controlada, los investigadores nunca lograron obtener financiamiento.
No fue la única vacuna que quedó suspendida. Decenas de científicos alrededor del mundo pararon sus estudios debido a la falta de interés y de fondos para seguir investigando.

Tal como le dijo a la BBC Susan Weiss, profesora de microbiología de la Universidad de Pensilvania, cuando acabó la epidemia, después de 7 y 8 meses, la gente, los gobiernos y las farmacéuticas “perdieron interés de inmediato en el estudio de los coronavirus”.
“Pero además, el SARS afectó principalmente a Asia, con unos casos en Toronto (Canadá) pero no llegó a Europa como este nuevo coronavirus”.
“Después surgió MERS, el segundo coronavirus humano virulento, y ese quedó casi totalmente confinado en Medio Oriente”.
“Después se disiparon los coronavirus y el interés por ellos. Hasta ahora. Y realmente creo que debíamos haber estado mejor preparados”, afirma la investigadora.
Dos advertencias
El SARS y el MERS, dicen los expertos, fueron dos “advertencias increíbles” sobre los peligros de los coronavirus y aún así, no se continuó con los esfuerzos para seguir investigándolos.
Aunque la vacuna de la doctora Bottazzi era para un coronavirus distinto del que circula actualmente, los expertos coinciden en que si hubiera estado lista esa vacuna se hubiera avanzado mucho más rápido en el desarrollo de una nueva inoculación para futuras epidemias.
Jason Schwartz, profesor de la Escuela de Salud Pública de la Universidad de Yale, asegura que la preparación para esta pandemia tuvo que haber empezado desde el brote de SARS en 2002.
“Si no hubiéramos abandonado el programa de investigación de vacunas de SARS, hubieramos tenido listo muchos más fundamentos para trabajar en este nuevo virus que está cercanamente relacionado”, le dijo a la revista The Atlantic.
En efecto, el nuevo coronavirus, llamado Sars-Cov-2, es “primo cercano” del coronavirus que causó el Sars de 2002.
Ambos virus son, genéticamente, 80% similares, dice la doctora Bottazzi, y como su vacuna ya había pasado por los procesos necesarios para su aprobación esta hubiera podido adaptarse más rápidamente al nuevo coronavirus.
“Hubiéramos tenido ya un ejemplo de cómo se comportan este tipo de vacunas y aunque los virus no son exactamente iguales vienen de la misma clase”, le explica la investigadora a BBC Mundo.
“Tendríamos ya la experiencia de ver dónde surgen problemas con la vacuna y cómo resolverlos. Porque ya vimos cómo se comportó preclínicamente la vacuna del SARS y esperaríamos que la nueva vacuna se comporte relativamente igual”.
“Ya hubiéramos podido tener un perfil de seguridad en humanos”, agrega, “y más confianza en que estas vacunas se pueden usar en las poblaciones que las necesitan”.
“Terrible propuesta empresarial”
Si se hubiera tenido todo este conocimiento ahora, ¿por qué entonces se suspendió la investigación de vacunas contra los coronavirus?
Todo, dicen los expertos, se resume a los fondos disponibles para la investigación.
“No estábamos pidiendo 100 ni 1.000 millones de dólares”, señala la codirectora de la Escuela Nacional de Medicina Tropical de Houston.
“Estábamos hablando de tres o cuatro millones de dólares. Con un millón y medio hubiéramos podido hacer un estudio clínico para tener un perfil en humanos. Pero nos pararon justo cuando estábamos a punto de tener una evidencia interesante”.

Pero el financiamiento se acabó porque no había un mercado para la vacuna, como explica Peter Kolchinsky, virólogo y director de la compañía de biotecnología RA Capital.
“La realidad es que cuando hay un mercado, hay una solución”, le dice a la BBC.
“Hoy en día contamos con cientos de vacunas para coronavirus, pero todas son para animales: cerdos, pollos, vacas, etc.”.
Estas son vacunas para prevenir enfermedades que pueden costar millones de dólares a la industria avícola y ganadera.
Y se había pensado que los brotes de coronavirus en humanos podían ser controlados.
“El problema es que para cualquier compañía es una terrible propuesta empresarial desarrollar un producto que, según las probabilidades, no será utilizado en décadas o quizás nunca”.
“Este es el tipo de cosas donde los gobiernos deben invertir. Si esto hubiera sido una prioridad no tengo dudas de que las agencias gubernamentales hubieran financiado el continuo desarrollo de una vacuna para Sars” señala Kolchinsky.
“Y quizás habríamos estado mejor preparados para reaccionar al covid-19”, agrega.
Nueva vacuna
La realidad ahora es que se necesita una vacuna contra el coronavirus que causa covid-19.
Y lo más probable es que esta no esté lista hasta dentro de varios meses, quizás entre 12 y 18.

Quizás para entonces la pandemia podría estar ya controlada.
La doctora Bottazzi y su equipo están trabajando tanto en la actualización de la vacuna de Sars de 2016, como en una nueva vacuna para covid-19.
Y continúan tratando de encontrar financiamiento para su investigación.
“Los donantes nos han dado dinero para mover rápido la vacuna de 2016. Y los Institutos Nacionales de Salud nos dieron un pequeño subsidio de US$400.000 para empezar el desarrollo de la (nueva vacuna) covid-19. Pero tenemos que seguir convenciendo a los donantes para tener dinero para acelerarla”.
Todo el proceso, dice la investigadora, es “muy frustrante”.
“Nosotros en los laboratorios queremos desarrollar estas vacunas, pero no hay el apoyo financiero ni el apoyo de entidades gubernamentales que nos den fondos para la investigación”, le dice a BBC Mundo María Elena Bottazzi.
“Porque no tenemos programas sostenibles y las prioridades cambian de acuerdo a lo que está ocurriendo en momento”.
